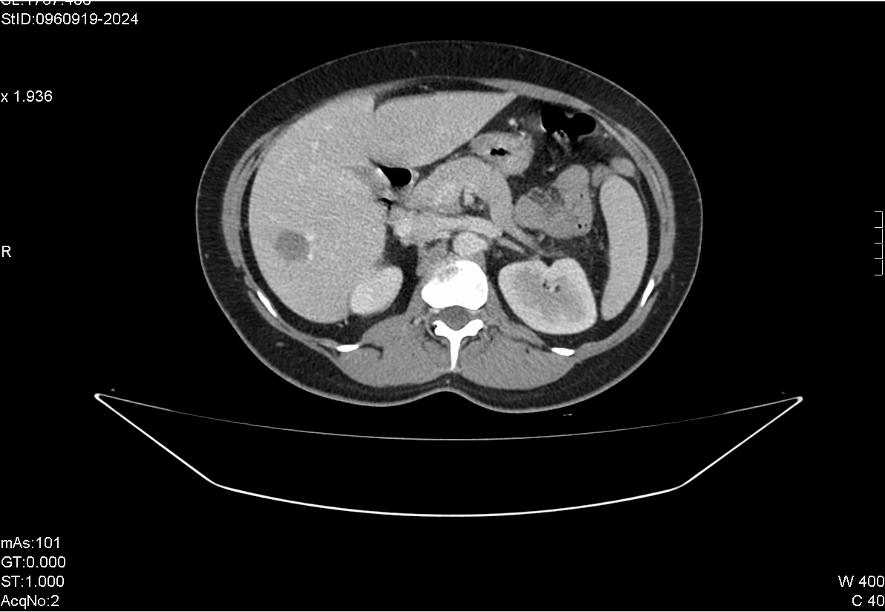

X Jornadas de Actualización en Medicina de Urgencias y VI Jornadas de Ecografía de la semFYC
6-7-8 de febrero de 2025
Antecedentes personales relevantes, anamnesis, exploración física y lugar que ocupa en ella la ecografía
Mujer, 50 años, dolor abdominal, estreñimiento y dificultad para la expulsión de gases de 7 días. No náuseas ni vómitos. Pico febril único de 38,5 ºC. Valorada previamente, diagnóstico de ITU, realizado ciclo antibiótico sin mejoría. FUR hace una semana, flujo vaginal aumentado, amarillento, no maloliente. Niega dispareunia.
A la exploración RHA de tonalidad normal. Abdomen blando y depresible, sin masas. Dolor a la palpación en FII, sin irritación peritoneal.
Analíticamente, leucocitosis 16120 (76,9% neutrófilos), trombocitosis 455000, y elevación de PCR, 154,3 mg/L. Elevación de LDH 290 U/L y GPT, 90 U/L.
Radiografía abdominal, sin datos de obstrucción intestinal.
Descripción de los hallazgos ecográficos y las imágenes más relevantes para la resolución del caso
Hígado de ecoestructura conservada, en LHD lesión hiperecoica redondeada de bordes lisos de unos 2 x 1,8 cm. A nivel de pelvis menor, paramedial izquierdo al cuerpo uterino, lesión redondeada heterogénea de bordes definidos, que parece depender de ovario y trompa izquierdos. No líquido libre abdominal.
Otras pruebas complementarias realizadas (si existen)
Ante la sospecha de EIP, TAC abdominal, confirma colección multiloculada en hemipelvis izquierda, en probable localización parametrial, sugestiva de absceso tubo-ovárico. Cambios inflamatorios locorregionales con leve engrosamiento de un segmento corto de sigma adyacente probablemente por contigüidad. Lesión focal hepática inespecífica, que en el contexto no permite descartar absceso secundario a embolismo séptico.
Juicio clínico, diagnóstico diferencial, concordancia con el hospital (en su caso)
Juicio clínico: Enfermedad inflamatoria pélvica con absceso tuvovárico izquierdo.
Diagnóstico diferencial: Diverticulitis aguda, embarazo ectópico, ITU, PNA, obstrucción intestinal.
Decisiones adoptadas: tratamiento, planes de actuación
Interconsulta Ginecología.
Evolución y seguimiento
Alta con cefixima y metronidazol. Seguimiento en consultas con buena evolución. Pendiente de RMN para categorizar lesión hepática.
El dolor abdominal es una consulta frecuente. La etiología es muy variada, los síntomas, en muchos casos semejantes, dificultando alcanzar un diagnóstico de certeza. En mujeres debemos tener en cuenta la patología ginecológica dentro del diagnóstico diferencial.
Ecográficamente la EIP suele cursar con dilatación de la trompa, no visible en condiciones normales, y en ocasiones se pueden visualizar mediante Doppler, vasos anexiales prominentes.
La ecografía clínica es una herramienta potente, para aportar in situ datos más allá de los obtenidos en la anamnesis, exploración y analítica, permitiendo orientar el diagnóstico, y solicitar otras pruebas de manera dirigida, acortando el tiempo al diagnóstico, y acelerando el inicio del tratamiento adecuado, en patologías en las que en muchos casos, su pronóstico depende de la celeridad en la instauración del mismo.